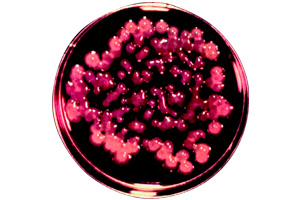

Brand Story
The Tetrapod zinc oxide (t-ZnO) was developed in 2012 by the Keele University, which ranks 23rd in Germany and has a history of more than 350 years.
Science Team
The result of joint research conducted by Dr. Rainer, Chair of Functional Nanomaterials at Kiel University, and a research team of 14 scientists
Honor & Patents
137 invention patents
Awarded the Germany Life Science Science4Life Award,and recipient of the Petersen Innovations-Transfer-Preis 2023

Acne Serum
Made purely in Germany, each bottle contains 30 milliliters. Its main active ingredients are t-ZnO and Sodium Hyaluronate: <100 KDA. It has a powerful non-hormonal anti-inflammatory effect, can deeply clean pores and prevent the formation of new blockages; at the same time, it has the effects of controlling oil, shrinking pores, smoothing the skin, promoting cell regeneration, and accelerating scar healing and fading. It can effectively relieve redness and swelling, treat skin rashes, pimples, pustules, nodules, cysts, acute and chronic acne, as well as stubborn acne, especially effective for inflammatory acne caused by bacteria.
The most effective acne essence in the world! Results in 3 days!
The world's only major invention with 137 patents for treating acne —— t-ZnO!
Organic Ingredients
Our essence liquid uses a lot of natural extracts to ensure the safety of sensitive skin

Sodium Hyaluronate: <100 KDA
Grape seed stem cells

Antarctic Glacier Glycoprotein
Customer Witness
Unique, revolutionary, and effective!
WIth the only active ingredient in the world, quadrupedal zinc oxide (t-Zn0),we have set a new standard for combating acne and skin pollution



Before use vs. after 3 days of use
Before use vs. after 7 days of use
Before use vs. after 22 days of use.


A major revolution in skin care
Say goodbye to acne and reshape the skin
Each bottle of phistoneag acne essence contains 30 milliliters. Its main active ingredients are t-ZnO and Sodium Hyaluronate: <100 KDA. It has a powerful non-hormonal anti-inflammatory effect, and also has the effects of shrinking pores, promoting cell regeneration, and accelerating scar healing and fading. It can effectively relieve redness and swelling, treat skin rashes, pimples, pustules, acute and chronic acne, as well as stubborn acne. It is especially effective for inflammatory acne caused by bacteria and is suitable for all skin types.






